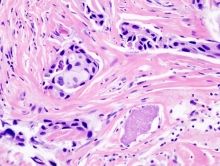

News
Latest cancer Policy News from ecancer.org
Regardless of their stage or type, cancers appear to share a telltale signature of widespread changes to the so-called epigenome, according to a team of researchers. In a study published online in Genome Medicine, the investigators say they have found widespread and distinctive changes in a broad variety of cancers to chemical marks known as methyl groups attached to DNA, which help govern whether genes are turned “on” or “off,” and ultimately how the cell behaves. Such reversible chemical marks on DNA are known as epigenetic, and together they make up the epigenome.
Continue Reading »Research presented at the 29th Annual International Papillomavirus Conference shows that a therapy being developed by Hera Therapeutics Inc. combats three types of human papillomavirus, including the two that cause 70 percent of all cervical cancer. When tested in several cultured human cell models, HTI-1968 blocked the replication of HPV-16, HPV-18 and HPV-11 cells, according to Louise T. Chow, Ph.D. and Thomas Broker, Ph.D., who presented the findings at the Seattle conference. The National Institute of Allergy and Infectious Diseases in the National Institutes of Health funded Chow’s work at the University of Alabama, Birmingham.
Continue Reading »Bcl-2-like protein 11 (BIM) deletion in advanced non-small cell lung cancer (NSCLC) is associated with shorter progression free survival (PFS) in epidermal growth factor receptor (EGFR) tyrosine kinase inhibitor (TKI) or chemotherapy treated Asian patients. Also, BIM deletion independently predicts overall survival (OS) of advanced NSCLC patients. The BIM protein can activate the programmed cell death also known as the apoptotic pathway in cells. BIM deletion has been detected in 12.8% of the Asian population but is very rarely observed in the Caucasian population. All NSCLC patients treated with any therapy, targeted or chemotherapeutic, ultimately fail their therapy but at varying times.
Continue Reading »Women treated for the cancer Hodgkin lymphoma will be able to better understand their risks of future infertility after researchers estimated their risk of premature menopause with different treatments. The findings, set out in the Journal of the National Cancer Institute, are based on the experience of more than 2,000 young women in England and Wales treated for the cancer over a period of more than 40 years. Previous research has suggested that women with Hodgkin lymphoma who receive certain types of chemotherapy or radiotherapy are at increased risk of going through the menopause early – but there was insufficient information to provide patients with detailed advice. But the new study, led by scientists at The Institute of Cancer Research, London, provides precise estimates of risk for women depending on which treatment types and doses they received and at what age – allowing doctors to give them detailed advice about their risks of future infertility.
Continue Reading »Non-alcoholic fatty liver disease (NAFLD) is a common affliction, affecting almost 30 percent of Americans, with a significant number suffering from its most severe form, called non-alcoholic steatohepatitis or NASH, which can lead to cirrhosis and liver cancer. In recent years, NASH has become the leading cause of liver transplantation. Development of effective new therapies for preventing or treating NASH has been stymied by limited small animal models for the disease. In a paper published online in Cancer Cell, scientists at the University of California, San Diego School of Medicine describe a novel mouse model that closely resembles human NASH and use it to demonstrate that interference with a key inflammatory protein inhibits both the development of NASH and its progression to liver cancer.
Continue Reading »Two Northwestern University scientists have identified a biomarker strongly associated with basal-like breast cancer, a highly aggressive carcinoma that is resistant to many types of chemotherapy. The biomarker, a protein called STAT3, provides a smart target for new therapeutics designed to treat this often deadly cancer. Using breast cancer patient data taken from The Cancer Genome Atlas, molecular biologists Curt M. Horvath and Robert W. Tell used powerful computational and bioinformatics techniques to detect patterns of gene expression in two cancer subtypes. They found that a small number of genes are activated by STAT3 protein signalling in basal-like breast cancers but not in luminal breast cancers. Basal-like cancer is a category that includes a number of different breast cancers, including the highly aggressive form called triple negative cancer.
Continue Reading »A protein named p66ShcA shows promise as a biomarker to identify breast cancers with poor prognoses, according to research published ahead of print in Molecular and Cellular Biology. Cancer is deadly in large part due to its ability to metastasise, to travel from one organ or tissue type to another and malignantly sprout anew. The vast majority of cancer deaths are associated with metastasis. In breast cancer, a process called “epithelial to mesenchymal transition” aids metastasis. Epithelial cells line surfaces which come into contact with the environment, such as skin and the gastrointestinal tract.
Continue Reading »A team of scientists led by Research Associate Professor Motomi Osato and Professor Yoshiaki Ito from the Cancer Science Institute of Singapore (CSI Singapore) at the National University of Singapore (NUS) found that a drug originally designed for killing a limited type of cancer cells with DNA repair defects could potentially be used to treat leukaemia and other cancers. The new study suggests that treatment with poly (ADP-ribose) polymerase (PARP) inhibitors, together with standard chemotherapy drugs, could be more effective in combating leukaemia. In the same study, researchers found that the inactivation of RUNX genes causes DNA repair defects and promotes the development of leukaemia and other cancers.
Continue Reading »